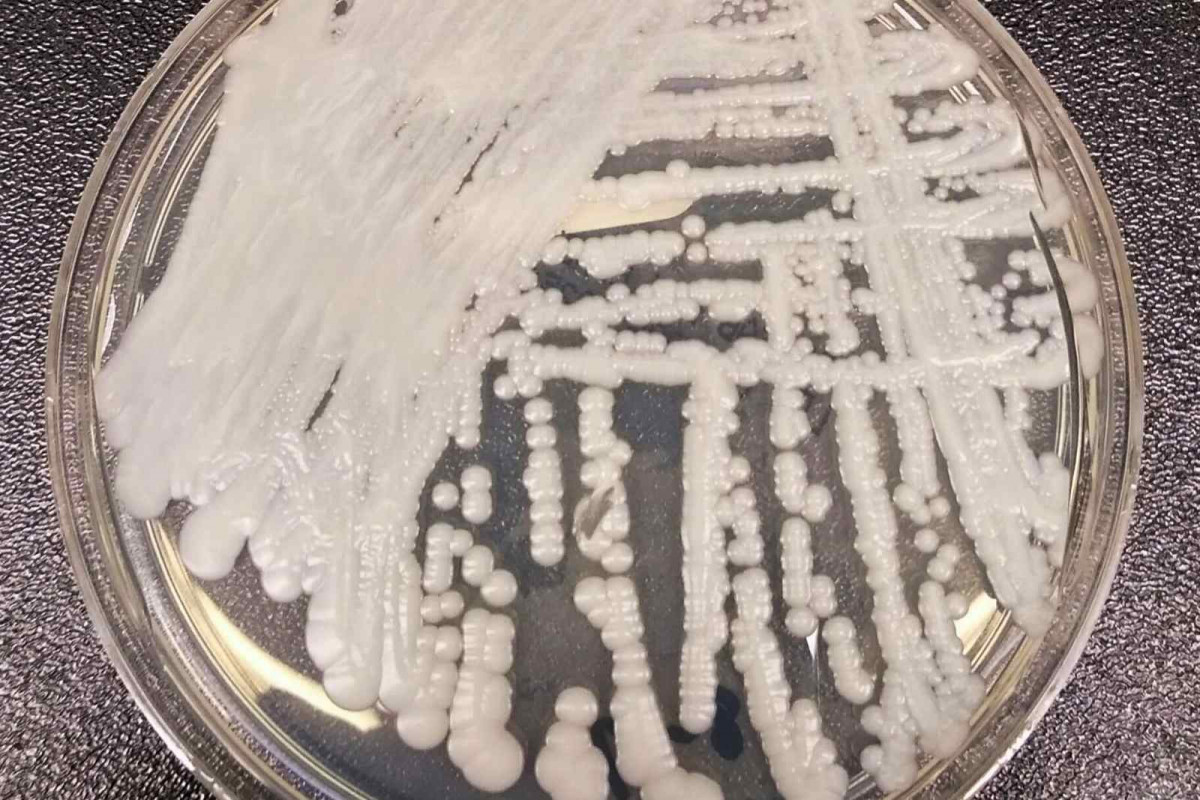

Alarma sanitària: un fong letal s'està propagant pels hospitals d'Espanya
Entre 2013 i 2023 es van detectar més de 1.800 infeccions, sobretot en hospitals. El patogen, resistent als fàrmacs, preocupa pels brots en pacients crítics
El Centre Europeu de Prevenció i Control de Malalties (ECDC) ha posat Espanya al centre de les alertes sanitàries després de confirmar que és el país de la Unió Europea amb més infeccions pel fong Candidozyma auris —conegut fins fa poc com Candida auris— entre 2013 i 2023. Segons l’informe publicat aquest dijous, del total de 4.012 casos notificats a Europa, 1.807 corresponen a Espanya.
Aquest fong, identificat per primer cop al Japó el 2009, ha esdevingut un autèntic repte per a la salut pública perquè té capacitat de resistir diversos fàrmacs antifúngics, es transmet fàcilment en entorns hospitalaris i afecta sobretot pacients crítics. Tal com recull Eldiario.es, la infecció pot derivar en candidèmia, és a dir, una infecció a la sang, que en persones amb el sistema immunitari debilitat pot ser mortal.
Per què és tan perillós?
Segons els experts del ECDC, el Candidozyma auris es propaga principalment entre pacients ingressats a les unitats de cures intensives (UCI). El contacte amb fluids corporals o amb material mèdic contaminat és la via principal de transmissió. La seva resistència a diversos tractaments dificulta el control i fa que els brots siguin difícils de contenir.
Preocupa especialment perquè provoca brots en hospitals i perquè molts pacients crítics tenen poques defenses per combatre’l, explica Juan Vicente Mulet Bayona, microbiòleg clínic al Consorci Hospital General de València, a Eldiario.es.
Espanya, en situació d’“endemicitat regional”
L’informe de l’ECDC assenyala que Espanya, juntament amb Grècia, Itàlia i Romania, ja no pot diferenciar si hi ha brots concrets, ja que el fong circula de manera constant. Aquesta fase epidemiològica s’anomena endemicitat regional i el nostre país hi va entrar el 2022, només sis anys després de detectar el primer cas el 2016.
Les dades mostren que la majoria d’infeccions s’han produït en uns pocs hospitals de la Comunitat Valenciana, on es van detectar els primers brots. Malgrat això, els experts insisteixen que gràcies a la introducció de protocols de vigilància i mesures de control, la incidència ha baixat en els últims anys.
Un problema europeu amb vigilància insuficient
Tot i la magnitud del problema, només 9 dels 36 països que van enviar dades al ECDC el 2024 disposaven d’un sistema específic de vigilància per a aquest patogen. Espanya, sorprenentment, no és un d’ells. Això fa pensar que les xifres oficials podrien ser només “la punta de l’iceberg”.
Els especialistes coincideixen que el repte és doble: millorar la detecció precoç i aplicar mesures estrictes de control hospitalari per evitar la propagació. “No és inevitable que s’estengui; tot depèn de la rapidesa amb què s’identifiquin els casos i s’activin els protocols”, subratlla Diamantis Plachouras, cap de la secció d’Infeccions Associades a la Sanitat de l’ECDC.

Escriu el teu comentari